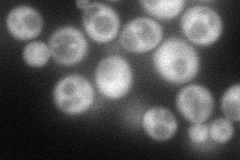
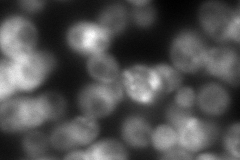
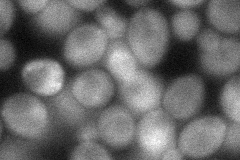
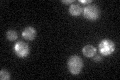

View description
Cytoplasmic GTPase-activating protein for Ypt/Rab transport GTPases Ypt6p, Ypt31p and Sec4p; involved in recycling of internalized proteins and regulation of Golgi secretory function
Localization:
Intensity:
Fold change:
Significance:
-
C’ GFP library in SD

cytosol24.92 -
N' NOP1pr-GFP in SD
cytosol,punctate94.3417 -
N' TEF2pr-mCherry in SD
cytosol8.80318 -
N' NATIVEpr-GFP in SD

cytosol27.2365 -
N' TEF2pr-VC and Cyto-VN in SD
cytosol52.6894 -
C’ GFP library in SD+DTT

punctate, budN/AN/ANo -
C’ GFP library in SD+H2O2

cytosol26.11.04No -
C’ GFP library in Starvation Media
punctateN/AN/AYes -
C’ GFP library on the background of Pup2-DaMP

cytosol -
C’ GFP library on the background of CCT mutant

cytosol27.90011.1195No
